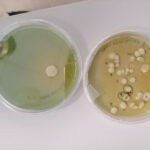

-
Valorizzazione dei lieviti autoctoni
Da sempre alla ricerca di un prodotto unico che possa rappresentare al meglio e con unicità la nostra azienda nel panorama del Valdobbiadene DOCG, abbiamo iniziato nel 2022 un progetto di ricerca per valorizzare i lieviti indigeni presenti in un
-
Il frizzante sui lieviti senza solfiti aggiunti: il nostro “12”
Dopo la pausa produttiva della scorsa annata, quest’anno è nuovamente disponibile il nostro “12”, il frizzante sui lieviti senza solfiti aggiunti. La nostra cantina ha prodotto i primi vini senza solfiti aggiunti nella vendemmia del 2012, anno in cui abbiamo intrapreso
-
Stramaret @ Primavera del Prosecco Superiore 2022
Al via l'edizione 2022 della Primavera del Prosecco. La nostra cantina partecipa alle Mostre di: San Pietro di Barbozza dal 16 al 30 aprile Col San Martino dal 3 al 22 maggio San Giovanni dal 1 al 5 giugno Una bellissima occasione per conoscere la
-
Degustazione in Malga @ Spumeggiante Cesen 2021
Siamo presenti con i nostri Valdobbiadene DOCG all’evento “Spumeggiante Cesen – le cantine del Conegliano Valdobbiadene Prosecco Superiore Docg salgono in malga al chiaro di luna”, organizzato da Confagricoltura Treviso che si terrà il 23 luglio 2021 dalle 18.00 alle
-
Medaglia d’Oro Concours Mondial de Bruxelles
🥇 Medaglia d'oro per il nostro Manzoni Bianco 6.0.13 al Concours Mondial de Bruxelles. Per una cantina che vinifica principalmente Valdobbiadene DOCG, ricevere un riconoscimento internazionale per un vino fermo è una gratificazione particolarmente importante, perché testimonia la qualità di tutte
-
Una storia legata al Prosecco
La nostra tradizione vitivinicola inizia nel lontano 1888, quando Giovanni Stramare fondò a Funer di Valdobbiadene l'omonima azienda agricola. Dal 2005 l'azienda ha ufficialmente il nome di Stramaret ed è una delle storiche cantine del valdobbiadenese. Tra i vini prodotti spiccano
-
Valdobbiadene DOCG Extra Brut
Zero residui zuccherini e selezione rigorosa delle uve: il nostro Valdobbiadene DOCG Extra Brut L'inserimento della nuova tipologia Extra Brut nel disciplinare produzione dei vini a denominazione di origine controllata e garantita “Conegliano Valdobbiadene Prosecco”, avvenuto nel 2019, ci ha permesso
-
Vendemmia 2020 – Annata di qualità
Un’annata di qualità: la soddisfazione della conversione al biologico La soddisfazione per la qualità raggiunta nella vendemmia di quest’anno è molta e riguarda in particolar modo la nostra produzione di vino biologico. Infatti, a partire dal 2016 le nostre uve possono fare
-
DOC, DOCG, IGP, IGT: quali sono le differenze?
Il mondo dei vini è fatto di sigle e categorie di cui spesso si sente parlare. Un po’ meno spesso però sono conosciute le differenze e i significati. Ve le proponiamo oggi, facendo un po’ di chiarezza. D.O.C. ovvero Denominazione di Origine Controllata Certifica
-
NOVITÀ 2020: Vino sfuso biologico IGT Glera
IGT GLERA COLLI TREVIGIANI è il nuovo vino sfuso biologico disponibile da quest’anno nei pratici Bag in Box da 5 lt. Un vino fermo che si può consumare direttamente dal Bag, dove conserva le qualità e le proprietà e non necessita l’imbottigliamento. La Glera è un
-
Vieni a trovarci alla Primavera del Prosecco
Le giornate più lunghe e il loro tepore che invita a stare all’aperto, sono l’annuncio che la primavera è arrivata e con lei anche la rassegna di eventi che caratterizzano la Primavera del Prosecco prevista da marzo a giugno. La
-
Una stagione che conferma l’eccellenza vincente dei vini Stramaret
Il Valdobbiadene Prosecco DOCG Spumante Extra Dry e Valdobbiadene Prosecco DOCG Spumante Brut continuano a collezionare riconoscimenti per la loro eccellenza e bontà, riempiendo di orgoglio noi di Stramaret. Il nostro Extra Dry ha guadagnato la medaglia d’oro al Concours Mondial de Bruxelles, svoltosi
-
Procedure e “storia recente” del vino Bio
Si fa presto a dire “vino bio”, ma la strada che permette di riportare questa dicitura in etichetta è ben più lunga e ricca di regole da rispettare. Una storia recente La normativa che regola la produzione di vino biologico è una
-
Vino Stramaret: la tua scelta biologica, il nostro impegno per la terra
Dal 2016 la cantina Stramaret è certificata dall'Organismo di Controllo Autorizzato MI.P.A.A.F. IT-BIO-015, ma cosa vuol dire? Per noi significa sviluppare un modello sostenibile che valorizzi le risorse del territorio e salvaguardi la salute del consumatore finale. Per la nostra cantina, ogni fase della
-
Stramaret è su Winetourism.com
Il 2020 non poteva iniziare meglio! Siamo orgogliosi di comunicarvi che l’azienda Agricola Stramaret è stata selezionata per entrare a far parte del portale svedese winetourism.com. Winetourism è una piattaforma mondiale di prenotazione online dedicata ai wine lovers. Il suo obiettivo
-
22° Concours Mondial de Bruxelles – Medaglia d’oro
Il nostro Valdobbiadene DOCG Extra Dry si è aggiudicato la medaglia d'oro alla ventiduesima edizione del Concours Mondial de Bruxelles, punto di riferimento mondiale per le competizioni enologiche. Il concorso ha l’obiettivo di riconoscere e far conoscere ai consumatori i
-
24ª edizione del Concours Mondial de Bruxelles: Medaglia d’argento
La giuria del Concours Mondial de Bruxelles, composta da degustatori provenienti da tutte le regioni del mondo, ha conferito al nostro Extra Dry 2016 e Brut 2016 la medaglia d’argento, nella categoria Prosecco di Valdobbiadene DOCG. Il processo di selezione
-
Cantina Stramaret: Azienda Biologica Certificata
Dopo il graduale processo di conversione, la nostra cantina ha ricevuto la certificazione di Azienda Biologica Certificata per la produzione di vino bio. Il percorso di conversione all’agricoltura biologica, durato 3 anni, ha visto il rinnovamento dei metodi di lavoro in favore dell’impiego
-
Un altro prestigioso premio per il nostro Extra Dry
Questa volta l’occasione è la Primavera del Prosecco, nell’ambito del Concorso Enologico Fascetta d’Oro, primo e unico concorso nazionale dedicato esclusivamente al Conegliano Valdobbiadene (patrocinio da UNPLI Treviso e Assoenologi). Quest’anno il concorso ha visto la partecipazione di 77 aziende, con
-
Il nostro vino senza solfiti
I solfiti sono sostanze sempre presenti nel vino, perché si generano naturalmente in seguito ai processi di fermentazione alcolica. I solfiti svolgono un’azione antiossidante che permette al vino di conservare nel tempo le proprie qualità organolettiche. I solfiti in piccole quantità
-
Vino Frizzante sui Lieviti Senza Solfiti
Dal mese di giugno è disponibile il nostro vino senza solfiti annata 2014: sano, gustoso e in armonia con la natura! Venite a trovarci nella nostra cantina. Passeggiare tra i filari, immersi nel verde, in queste bellissime giornate di sole è
-
42° Premio Douja d’Or 2014
MEDAGLIA PER IL NOSTRO VALDOBBIADENE SPUMANTE EXTRA DRY DOCG 2013 Il nostro Valdobbiadene Spumante Extra Dry 2013 ha ricevuto il premio Douja D’or durante la quarantaduesima edizione del celebre Concorso Enologico nazionale, che si svolge annualmente nella città di Asti. Il Concorso,
-
Concorso Enoconegliano 2014
Concorso Enologico Regionale – Selezione Vini Veneti Diploma di Merito per il nostro Valdobbiadene DOCG Brut ed Extra Dry EnoConegliano è un concorso enologico annuale indetto dall’Associazione Dama Castellana di Conegliano (Treviso) in collaborazione con Assoenologi (Associazione Enologi Italiani). La manifestazione si
-
Concorso Enologico Selezione del Sindaco
La nostra cantina ha partecipato al Concorso Enologico Selezione del Sindaco 2014 con il Conegliano Valdobbiadene Prosecco nelle versioni Extra Dry e Brut, ottenendo la medaglia d’argento su 248 vini iscritti della Regione Veneto e un totale di 947 vini italiani e internazionali. Il
-
Il Valdobbiadene DOCG va in scena con “Calici di Stelle”
Domenica 10 Agosto 2014 dalle ore 19.30 si apre il sipario per il tradizionale appuntamento con “Calici di Stelle”, che si terrà presso il Parco di Villa del Cedri a Valdobbiadene. L’evento, giunto quest’anno alla sua decima edizione, è una delle
-
Canevando 2014
Il 29 Giugno si terrà la sedicesima edizione di CANEVANDO, un evento eno-gastronomico che prevede una passeggiata guidata tra le colline e i vigneti del Valdobbiadene DOCG. Durante il tragitto i partecipanti potranno conoscere e visitare le cantine che incontreranno
-
Divinicolli 2014 La grande festa del Valdobbiadene DOCG
Al via la seconda edizione di Divinicolli che si svolgerà Domenica 8 giugno a Valdobbiadene. Divinicolli è una manifestazione eno-gastronomica, che unisce il gusto per la scoperta dei sapori tipici del territorio, con il piacere di trascorrere una giornata all’aperto, immersi
-
Primavera del Prosecco 2014
Anche quest’anno la nostra cantina partecipa alla ‘Primavera del Prosecco’, il tradizionale evento dedicato al Prosecco che quest’anno giunge alla sua 19° edizione. Una rassegna apprezzata dagli amanti dei nostri pregiati vini ma anche da tutti coloro che apprezzano la natura,
-
Primavera del Prosecco 2014 Arrivederci al prossimo anno!
Il 27 giugno si è ufficialmente conclusa la ‘Primavera del Prosecco’. Presso l’Aula Magna del Campus dell’Università di Agraria a Conegliano si è tenuta la cerimonia conclusiva della manifestazione. La diciannovesima edizione della Primavera del Prosecco Superiore, ha ospitato 15 mostre
-
I nostri vini sono stati premiati al EnoConegliano 2017
Il nostro Prosecco DOCG Superiore Spumante Brut Vino Biologico 2016 ha ricevuto il Sigillo d’Argento al 19° EnoConegliano. EnoConegliano è la prestigiosa manifestazione organizzata dall’Associazione Dama Castellana di Conegliano e viene realizzata in collaborazione con l’Associazione Enologi Enotecnici Italiani. Questo concorso è
-
Vino Biologico Stramaret: rispetto e amore per il territorio!
Noi di Stramaret nutriamo un grande rispetto e amore per il territorio, e da sempre adottiamo pratiche di coltivazione naturali nel rispetto delle tipicità del nostro terreno. Questo impegno è stato riconosciuto, dopo 3 anni di ammodernamenti, nel 2016 quando
-
Primavera del Prosecco 2013
Con l'arrivo della bella stagione si rinnova la 'Primavera del Prosecco', un grande evento per gli appassionati di enogastronomia e vini di qualità Valdobbiadene DOCG. La 'Primavera del Prosecco' giunge quest'anno alla sua 18° edizione, confermandosi uno degli appuntamenti più
Via Cal Dritta 81/b
31049 – Funer di Valdobbiadene – TV
Tel / Fax +39 0423.976437
P.IVA: 03963830264
#Stramaret_cantina